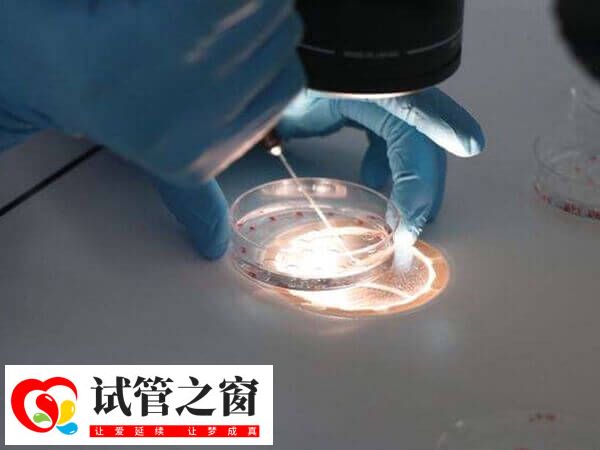
養囊的具體的費用會根據醫院收費標準而異

試管嬰兒胚胎養囊費多少錢
在試管養囊過程中,一般囊胚通常按個數收費,費用可能在1-2萬元左右,而培養的囊胚數量越多,那么費用也會相應增加,具體還要以實際為準,不可一概而論。此外,由于養囊是優勝劣汰的方式,可能并非養囊百分百成功,但因養囊的過程已經產生了,所以養囊失敗了也是需要收取一定費用的。
胚胎養囊費用怎么算的
大多數醫院的胚胎養囊費用,會根據養囊數量來計算費用,據相關信息了解,養成一個囊胚的價格是3千元左右,而最終每個養囊周期的費用則在1萬元至3萬元之間,而具體計算方法,如下所示:
- 囊胚培養費是按實際留養天數收費的,1200/天,除了解凍養囊移植的患者,其余不管新鮮胚胎還是解凍胚胎均是留養成功才收費;
- 如果最后冷凍的是第五天的胚胎就收兩天囊胚培養費,第六天的收三天培養費,再者每個人冷凍的管數不一定相同,冷凍當月還需交當月保存費110/管,封頂330元,故每個人費用會有不同。
根據上述內容可知,在試管嬰兒養囊過程中,患者胚胎養囊的具體的費用可能會根據醫院的具體收費標準,以及養囊的實際天數有所不同。而且不同的醫院收費標準可能有所不同,有的醫院可能采取按成功案例收費的方式,即不成功則不收費。
試管養囊失敗還收不收費
通常情況下,大多數醫院囊胚培育是按照個數收費,養囊的個數越多,費用就越高,而因養囊存在一系列影響因素,因此養囊胚需要另外收費。不過一般醫院只有在養囊成功后再收取相應的費用,但也有部分醫院是采取先收費再養囊的,具體根據醫院實際情況為準。
但是要注意的是,試管養囊無論成功還是失敗,因養囊的過程已經產生,且養囊時也使用一些培養器械和原料,所以做試管嬰兒養囊的患者,如果出現養囊失敗的情況,那么一般也是要收取一定費用的。





